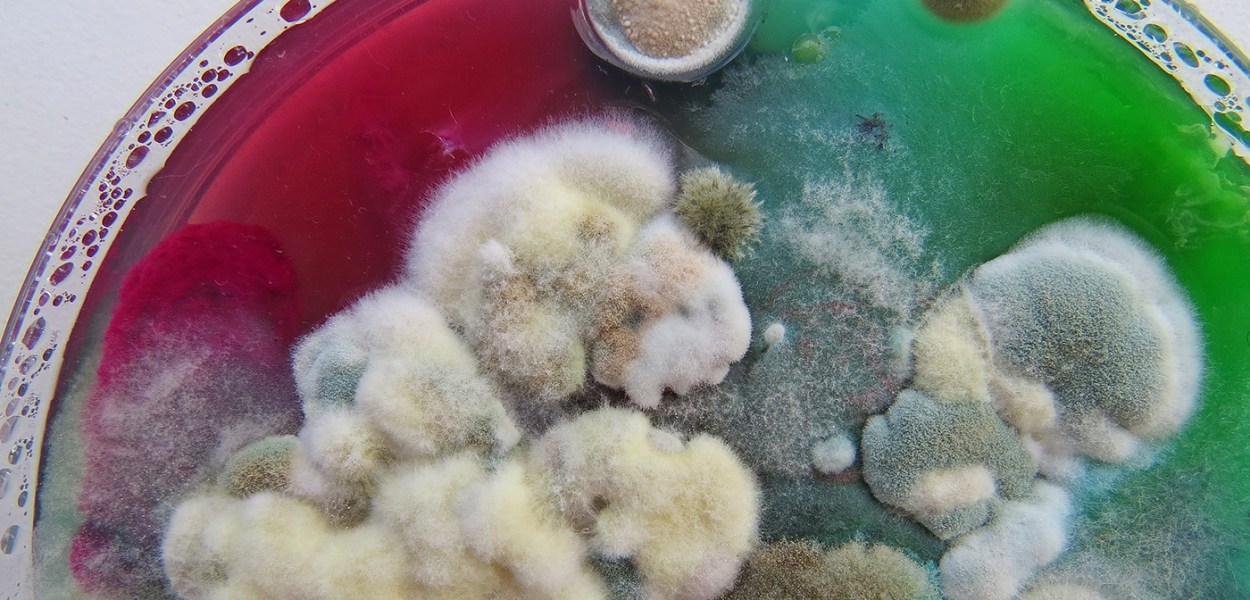
Dasha Plesen

OperArt – Lo sbiancamento dei coralli nelle sculture di carta di Rogan Brown
“‘La barriera corallina è un microcosmo di un macrocosmo’, afferma l’artista della carta Rogan Brown. ‘Ciò che sta accadendo oggi alle barriere coralline, alla fine accadrà al pianeta domani, a meno che non venga intrapresa un’azione’. Attraverso nuove sculture di carta composte da creature marine delicatamente frangiate, Brown […]

[…] boredpanda.com […]
[…] Streetart – Thiago Mazza @ Barentin, France […]
[…] Streetart – Smile @ Avis, Portugal […]
[…] Streetart – Kelvin Koubik @ Pelotas, Brazil […]
Sto cominciando a perdere colpi... pensavo di avere ricommentato :)